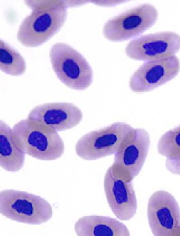
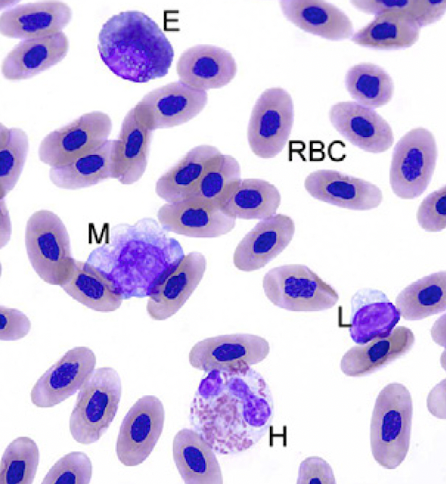

reptiles have — RBC
nucleated
CBC in reptiles includes
RBC- nucleated
WBC
thrombocytes (not platelets)
RBC lifespan in reptiles
600-800 days!
nucleated
when looking at cell slide, what bad things are you looking for
mitotic figures
hypochromasia- bluer, rounder
anisocytosis- different sizes
parasites
WBC for reptiles
Heterophils= neutrophils- 30-45%
Eosinophils- 7-20%
Basophils- 40+
Azurophils
Lymphocytes- 80%
Monocytes 0-20%
how to count WBC
10 fields
leukocyte count/10 X 2000

heterophils= neutrophils
heterophils= neutrophils, immunity, phagocytosis, 30-45% of WBC
heterophils toxic change
degranulation
basophilia
vacuoles
nuclear lobulation

heterophils= neutrophils, immunity, phagocytosis, 30-45% of WBC

eosinophils
* pink granules
* parasites
* 7-20% of WBC- higher in turtles

basophil
* smaller than heterophils/eosinophils
* dark purple granules
* function?
* 40% WBC
small lymphocytes can look similar to
thrombocytes


monocyte
* blue grey cytoplasm- chromatin loosely clumped
* chronic inflammation or infection

azurophils
* pale blue with small dark purple granules
* Hybrid – part granulocytes/part monocyte in structure and function
* Snakes = mammalian neutrophils
* Lizards = mammalian monocytes
instead of platelets reptiles have
thrombocytes

liver blood work for reptiles
aspartate aminotransferase
bile acids
creatine kinase
glucose
decreased AST
cirrhosis
amyloidosis
tissue enzume in liver and many other organs
— is measure of liver function
bile acids
Creatine kinase is a measurment of
muscle damage: cardiacm smooth or skeletal muscle
- can tell you if high AST is from liver, if CK low. or if from other organ if CK high
increased uric acid can mean
carnivore that just ate
renal diease
gout
- liver converts ammonia to urea and uric acid
- eliminated by kidneys
low albumin causes
renal loss
CKD
destruction (sepsis)
malnutrition
high globulin
chronic inflammation
active folliculogenesis
ruptured RBC/hemolysis will increase what lab findings
phosphorous
potassium
total protein
AST
lipemia will cause what on lab work
RBC lysis- decreased PCV
abbormally high- AST, uric acid, calcium


